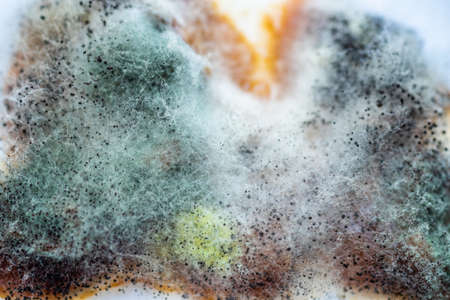

写真素材 - A piece of food covered with mold and pathogenic fungi rotates close-up
作品情報
A piece of food covered with mold and pathogenic fungi rotates close-up
- ID:153965981
- 作品種別:写真
- 作者名:Igor
キーワード
- bacterium
- bad
- brown
- bruise
- circular
- colorful
- colourful
- compost
- damaged
- depth of field
- eat
- focus
- food
- footage
- foul
- fruit
- fungal
- fungus
- garbage
- green
- inedible
- kernel
- loop
- macro
- mature
- meal
- mold
- moldy
- motion
- mould
- movement
- natural
- nature
- old
- organic
- peach
- poor
- ripe
- rot
- rotate
- rotation
- rotten
- rotting
- round
- spin
- spoiled
- ugly
- unhealthy
- waste
類似作品
Cottage cheese ...
Omelet with por...
vegetarian cutl...
Fried pork cutl...
Mold, fungus on...
Vegetarian joll...
Female hand put...
A studio photo ...
Waste plastic b...
Rectangular pla...
Styrofoam food ...
Mold in the ref...
Atlantic herrin...
a stack of home...
A hand is placi...
Banana Cake on ...
Junk food, frie...
Convenient but ...
The Yellow Roun...
shot of delicio...
Moldy expired f...
gilt head bream...
Picture of lunc...
Closed up moldy...
Canned Wild Pin...
Duck breast vac...
packed lunch
Cold noodles, b...
Tasty organic y...
Food Container ...
Frozen food in ...
Orange and choc...
open tin with d...
Foam dish garba...
Spanish lentils...
Rectangular pla...
Open vintage ti...
Delivery servic...
aging cheese he...
fresh and tasty...
Asian fresh spr...
Single-use plas...
A studio photo ...
Convenient but ...
Lard animal fat...
A studio photo ...
garbage from on...
Lunch box, frie...